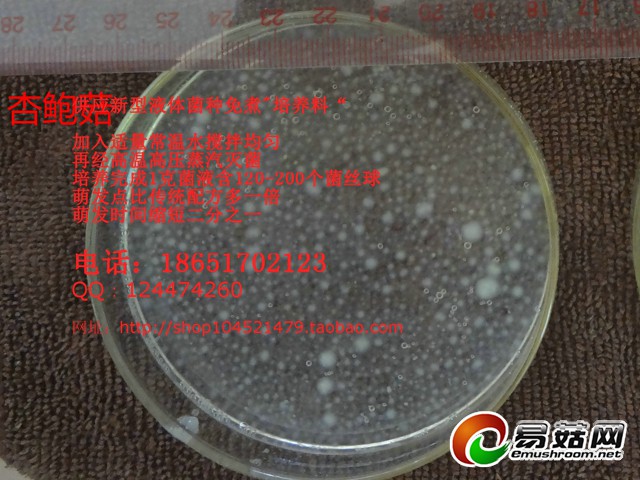
640 杏鲍菇14

供应液体菌种天然培养料 发酵罐千分之一接种量 成熟时间: 平菇 秀珍菇 杏鲍菇 木耳 猴头菇 虫草
雅康生物液体菌种免煮培养料特点:
一、 本店所经营ManBetX体育液体菌种专用培养基,各种优质原料经过严格筛选、测量、洗涤、调整比例
、蒸煮、精细过滤提纯、干燥、研磨成极细的可溶性粉末状,严格的生产管理制度保证各批次的活性指
标稳定,耐储存,使用方便,培养成熟后活力强,萌发快,菌丝球单位密度极高,是理想的现代液体菌
种培养基。基质为干燥粉末,灭菌器前按比例对入适量的冷水,充分搅拌溶解到无结块,再经普通医用
单层纱布过滤后即可装罐灭菌,灭菌后有少量沉淀为正常状态,培养成熟后菌液澄澈,恒温无光放置96
小时后对活性无影响。
二、 使用本产品所生产的液体菌液,菌丝活性比传统的菌液活性要高,萌发快,萌发点多,抗污染
能力强等优点
1、 每毫升菌液达到120-200个菌丝球
2、 菌丝萌发时间比目前普通培养液缩短二分之一
3、 菌丝封面时间比目前普通培养液缩短二分之一
4、 同等接种量,发酵罐培养时间比普通培养液快2-4天
5、 菌丝水洗后烘干重每升4-5克
6、 在出菇瓶/袋接种后,由于菌丝吃料封面快,污染也会减少,发菌满袋时间比传统培养液快2-7
天不等
三角瓶制作:
1、使用容量10升不锈钢圆桶作配液桶,盛入5升常温自来水。
2、如果客户订购的免煮培养料一包可配5升培养液,则加入一包该培养料到水中,使用搅拌棒等器具对
培养液进行搅拌,直到搅拌到无颗粒即可。
3、溶解后的培养液,从配液桶倒进三角瓶,大约占三角瓶容量的三分之二,水中大颗粒的固体物需要用
50目尼龙网纱做一次过滤,预防日后发生堵塞。
4、三角瓶灌装好培养液后,封上盖子,在2小时内进行高压蒸汽灭菌,温度121度,灭菌时间20-30分钟
不等,压力降到零后出锅,在干净环境自然冷却。
5、待三角瓶冷却到25度即可进行接种。一个三角瓶接入1cm*1cm PDA菌种即可,接种后使用旋转摇床,
转速200次/分钟、恒温25度、避光、不间断旋转培养,培养5-8天(视乎品种而定)即可接种到发酵罐。
发酵罐制作(200L):
1、使用容量250升不锈钢圆桶作配液桶,盛入180-200升常温自来水。
2、如果客户订购的免煮培养料一包可配100升培养液,则加入两包该培养料到水中,使用搅拌器、潜水
泵等器具对培养液进行搅拌,直到搅拌到无颗粒即可(约1-10分钟不等)。
3、溶解好的培养液,使用潜水泵从配液桶抽到发酵罐里面,水泵出水口需要包裹单层50目尼龙网纱,过
滤水中大颗粒的固体物,预防日后发生堵塞。
4、200升的发酵罐灌装好培养液后,在2小时内进行高压蒸汽灭菌,温度121度,灭菌时间40-70分钟不等
5、待发酵罐冷却到25度即可进行接种。一个发酵罐接种入一个三角瓶(300ml-600ml)液体原种后进行23
-25度的恒温培养,连续供气培养5-8(视乎品种而定)天为最佳使用时间。
6、接入出菇袋/瓶时,接种喷嘴喷出的液体压力需达到1.5公斤,以保证菌种的均匀度缩短萌发时间。